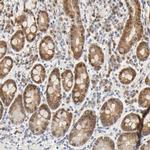
ACSS2 Antibody in Immunohistochemistry (IHC)

Search
Invitrogen
ACSS2 Polyclonal Antibody
{{$productOrderCtrl.translations['antibody.pdp.commerceCard.promotion.promotions']}}
{{$productOrderCtrl.translations['antibody.pdp.commerceCard.promotion.viewpromo']}}
{{$productOrderCtrl.translations['antibody.pdp.commerceCard.promotion.promocode']}}: {{promo.promoCode}} {{promo.promoTitle}} {{promo.promoDescription}}. {{$productOrderCtrl.translations['antibody.pdp.commerceCard.promotion.learnmore']}}
产品信息
PA5-52059
种属反应
已发表种属
宿主/亚型
分类
类型
抗原
偶联物
形式
浓度
规格
纯化类型
保存液
内含物
保存条件
运输条件
RRID
产品详细信息
Immunogen sequence: PGETTQITYH QLLVQVCQFS NVLRKQGIQK GDRVAIYMPM IPELVVAMLA CARIGALHSI VFAGFSSESL CERILDSSCS LLITTDAFYR GEKLVNLKEL ADEALQKCQE KGFPVRCCIV VKHLGRAELG MGDSTSQSPP IKRSCPDVQ
Highest antigen sequence identity to the following orthologs: Mouse - 91%, Rat - 90%.
靶标信息
This gene encodes a protein with a sterol sensing domain (SSD) and seven WD domains. In the presence of cholesterol, this protein binds to sterol regulatory element binding proteins (SREBPs) and mediates their transport from the ER to the Golgi. The SREBPs are then proteolytically cleaved and regulate sterol biosynthesis.
仅用于科研。不用于诊断过程。未经明确授权不得转售。
生物信息学
蛋白别名: AceCS1; acetate thiokinase; Acetate--CoA ligase; acetate-CoA ligase; Acetyl-CoA synthetase; Acetyl-CoA synthetase 1; acetyl-Coenzyme A synthetase 2 (ADP forming); Acetyl-coenzyme A synthetase, cytoplasmic; ACS; Acyl-activating enzyme; Acyl-CoA synthetase short-chain family member 2; cytoplasmic acetyl-coenzyme A synthetase; Propionate--CoA ligase; unnamed protein product
基因别名: ACAS2; ACECS; AceCS1; ACS; ACSA; ACSS2; dJ1161H23.1
UniProt ID: (Human) Q9NR19
Entrez Gene ID: (Human) 55902